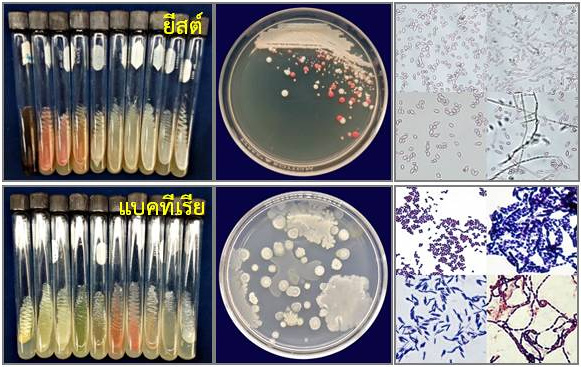

ผลิตภัณฑ์จากงานวิจัย |
 |
|
|
|
|
|
โปสเตอร์งานวิจัย |
 |
|
หน่วยจุลชีววิทยาประยุกต์
(Applied Microbiology Unit)
 |
งานวิจัย: ค้นคว้าวิจัยด้านจุลชีววิทยาโดยมุ่งเน้นการวิจัยด้านความหลากหลายของจุลินทรีย์และการประยุกต์ใช้ในด้านการเกษตร อุตสาหกรรม และสิ่งแวดล้อม ความหลากหลายของจุลินทรีย์จากระบบนิเวศต่างๆ เช่น ดินอินทรีย์ ดอกไม้ เป็นต้น
|
| |
|
|
งานบริการวิชาการ: ให้บริการทางวิชาการในรูปแบบต่างๆ เช่น ให้บริการอุปกรณ์ เครื่องมือวิทยาศาสตร์ การตรวจวิเคราะห์คุณภาพทางจุลชีววิทยาและชีวเคมี ให้คำปรึกษา แนะนำ ฝึกอบรมแก่นิสิต/นักศึกษา อาจารย์ นักวิจัย เกษตรกร และบุคคลทั่วไป
|
| |
1) |
งานบริการวิเคราะห์: บริการตรวจวิเคราะห์ทางด้านจุลินทรีย์ในผลิตผลทางการเกษตร น้ำอุปโภค-บริโภค ผลิตภัณฑ์อาหารและเครื่องดื่ม เช่น ปริมาณจุลินทรีย์ทั้งหมด (Total Plate Count; TPC) ปริมาณยีสต์และรา (Yeasts and Molds) จุลินทรีย์บ่งชี้ (Indicator Microorganisms) ได้แก่ Faecal Coliform Bacteria, Total Coliform Bacteria และ Escherchia coli (E. coli) แบคทีเรียสาเหตุโรคทางเดินอาหาร (Food borne Pathogens) ได้แก่ Salmonella spp. เป็นต้น การตรวจวิเคราะห์แบคทีเรียกลุ่ม Lactic Acid Bacteria และการทดสอบฤทธิ์ต้านจุลินทรีย์ (Sensitivity Test) |
| |
|
 |
| |
2) |
งานฝึกอบรม/ถ่ายทอดเทคโนโลยี: การเผยแพร่และถ่ายทอดความรู้ด้านจุลชีววิทยาให้แก่ นักเรียน นิสิต/นักศึกษา อาจารย์ นักวิจัยและนักวิชาการจากภาครัฐและเอกชน ตลอดจนผู้สนใจทั่วไป โดยจัดฝึกอบรมเกี่ยวกับด้านจุลชีววิทยา เช่น การฝึกอบรมโครงการเสริมทักษะวิทยาศาสตร์ด้านจุลชีววิทยา การฝึกอบรมเทคนิคด้านชีวโมเลกุลเบื้องต้นเพื่อการศึกษาและวิจัยความหลากหลายของจุลินทรีย์ และการฝึกอบรมการจัดจำแนกจุลินทรีย์ด้วยเทคนิคชีวโมเลกุล เป็นต้น รวมทั้งการจัดแสดงนิทรรศการในโอกาสต่างๆ การเยี่ยมชม และศึกษาดูงาน |
| |
|
   |
| |
|
   |
| |
|
   |
| |
3) |
งานสนับสนุนการผลิตบัณฑิต: งานสอนและร่วมสอนในหัวข้อที่เกี่ยวข้องกับความเชี่ยวชาญและประสบการณ์ของนักวิจัย ได้แก่ จุลชีววิทยาด้านอาหารและความปลอดภัยของอาหาร (Microbiology for Food and Food Safety) เทคนิคทางรีคอมบิแนนต์ดีเอ็นเอ (Advanced Techniques in Recombinant DNA) รวมทั้งการฝึกงานทางด้านจุลชีววิทยาให้แก่นิสิต/นักศึกษา |
| |
|
   |
| |
|
   |
บุคลากร
 |
นางสาวชมนาถ เกิดคง (Ms. Chommanat Kerdkhong) |
| ประวัติการศึกษา: |
วท.บ. (เกษตรศาสตร์) มหาวิทยาลัยเกษตรศาสตร์ วท.ม. (พฤกษ์เศรษฐกิจ) มหาวิทยาลัยเกษตรศาสตร์ ปร.ด. (วิทยาศาสตร์ชีวผลิตภัณฑ์) มหาวิทยาลัยเกษตรศาสตร์ |
| ตำแหน่ง: |
นักวิจัยชำนาญการ |
| สาขาที่เชี่ยวชาญ: |
ความหลากหลายของจุลินทรีย์ อณูชีววิทยา การทดสอบฤทธิ์ต้านจุลินทรีย์ (Sensitivity Test) |
| E-mail: |
rdicnke@ku.ac.th |
 |
นางสาวรัตติยา ผดุงผล (Ms. Rattiya Padungpol) |
| ประวัติการศึกษา: |
วท.บ. (จุลชีววิทยา) จุฬาลงกรณ์มหาวิทยาลัย วท.ม. (จุลชีววิทยาและเทคโนโลยีจุลินทรีย์) จุฬาลงกรณ์มหาวิทยาลัย |
| ตำแหน่ง: |
นักวิจัยปฏิบัติการ |
| สาขาที่เชี่ยวชาญ: |
จุลชีววิทยา |
| E-mail: |
fagrrip@ku.ac.th |
ผลงานวิชาการปัจจุบันย้อนหลังถึงปี พ.ศ. 2549
ผลงานวิจัยตีพิมพ์ในวารสาร |
| Bunsiri, A, J. Jirapothithum, Y. Onsiri, M. Tantirungkij, O. Chuantrakool and W. Sorapongpaisan. 2015. Sanitization of holy basil using ozonated water washing for quality maintenance and consumer safety. Agricultural Sci. J. 46:(3/1)(Suppl.): 323-326. |
| Bunsiri, A., C. Kunprom, S. Thongbor, C. Ruttanakitakul, R. Korpraditsakoo, M. Tantirungkij and O. Chountragoon. 2007. Loss of chilli between harvesting and delivering to the export company. Agricultural Sci. J. 38(5)(Suppl.): 66-69. |
| Chaeychomsri, W., S. Chaeychomsri, M. Tuntirungkij, P. Tabthipwon, N. Noparatnaraporn and V. Siriphovat. 2008. Characterization of microsatellite markers for the Siamese Crocodile and amplification in the closely related genus Crodylus. Kasesart J. (Nat. Sci.) 42: 682-692. |
| Jindamorakot, S., S. Ninomiya, S. Limtong, W. Yongmanitchai, M. Tuntirungkij, W. Potacharoen, K. Tanaka, H. Kawasaki and T. Nakase. 2009. Three new species of bipolar budding yeasts of the genus Hanseniaspora and its anamorph Kloeckera isolated in Thailand. FEMS Yeast Res. 9: 1327-1337. |
| Jindamorakot, S., S. Limtong, W. Yongmanitchai, M. Tuntirungkij, W. Potacharoen, H. Kawasaki, M. Tanticharoen and T. Nakase. 2008. Candida ratchasimensis sp. nov. and Candida khaoyaiensis sp. nov., two anamorphic yeast species isolated from flowers in Thailand. FEMS Yeast Res. 8: 955-960. |
| Jindamorakot, S., S. Limtong, W. Yongmanitchai, M. Tuntirungkij, W. Potacharoen, H. Kawasaki and T. Nakase. 2007. Two new anamorphic yeasts, Candida thailandica sp. nov. and Candida lignicola sp. nov., isolated from insect frass in Thailand. FEMS Yeast Res. 7: 1409-1414. |
| Nasanit, R., S. Jaibangyang, M. Tantirungkij and S. Limtong. 2016. Yeast diversity and novel yeast D1/D2 sequences from corn phylloplane obtained by a culture-independent approach. Antonie van Leeuwenhoek 109(12): 1615-1634. DOI: 10.1007/s10482-016-0762-x |
| Nasanit, R., A. Tangwong-o-thai, M. Tantirungkij and S. Limtong. 2015. The assessment of epiphytic yeast diversity in sugarcane phyllosphere in Thailand by culture-independent method. Fungal Biol. 119(12): 1145-1157. |
| Nasanit, R., K. Krataithong, M. Tantirungkij and S. Limtong. 2015. Assessment of epiphytic yeast diversity in rice (Oryza sativa) phyllosphere in Thailand by a culture-independent approach. Antonie van Leeuwenhoek 107: 1475-1490. |
| Rattanachuay, P., D. Kantachote, M. Tantirungkij, T. Nitoda and H. Kanzaki. 2011. Antivibrio compounds produced by Pseudomonas sp. W3: characterisation and assessment of their safety to shrimps. World J. Microbiol. Biotechnol. 27: 869–880. |
| Rattanachuay, P., D. Kantachote, M. Tantirungkij, T. Nitoda, and H. Kanzaki. 2010. Inhibition of shrimp pathogenic vibrios by extracellular compounds from a proteolytic bacterium Pseudomonas sp. W3. Electronic Journal of Biotechnology [online]. 13(1). Jan. 15, 2010, Available from Internet: http://www.ejbiotechnology.cl/content/vol13/issue1/full/2/index.html. ISSN 0717-3458. |
| Tantirungkij, M., R. Nasanit and S. Limtong. 2015. Assessment of endophytic yeast diversity in rice leaves by a culture-independent approach. Antonie van Leeuwenhoek 108: 633-647. |
ผลงานวิจัยตีพิมพ์ในเอกสารประชุมวิชาการ |
ชมนาถ เกิดคง, มณี ตันติรุ่งกิจ และ อรวรรณ ชวนตระกูล. 2558. การคัดแยกแบคทีเรียที่สร้างเอนไซม์ในกลุ่ม ไฮโดรเลสจากทางเดินอาหารของปลาน้ำจืด, หน้า 1611-1621. ใน เรื่องเต็มการประชุมวิชาการระดับชาติ มหาวิทยาลัยเกษตรศาสตร์ วิทยาเขตกำแพงแสน ครั้งที่ 12. 8-9 ธันวาคม 2558. มหาวิทยาลัยเกษตรศาสตร์ วิทยาเขตกำแพงแสน, จ. นครปฐม |
| ชมนาถ เกิดคง, อรวรรณ ชวนตระกูล, พัชราภรณ์ ภู่ไพบูลย์ และ มณี ตันติรุ่งกิจ. 2550. ศักยภาพของปาหมีในการต้านจุลินทรีย์. ใน เรื่องเต็มการประชุมวิชาการมหาวิทยาลัยเกษตรศาสตร์ วิทยาเขตกำแพงแสน ครั้งที่ 4. 6-7 ธันวาคม 2550. มหาวิทยาลัยเกษตรศาสตร์ วิทยาเขตกำแพงแสน, จ.นครปฐม. |
| ภคพร สารทลาลัย, อุทัยวรรณ ด้วงเงิน, อรวรรณ ชวนตระกูล, มณี ตันติรุ่งกิจ และ สุรัตน์วดี จิวะจินดา. 2556. องค์ประกอบทางเคมีของสารสกัดจากกลีบเลี้ยงกระเจี๊ยบแดง (Hibiscus sabdariffa) ด้วยเทคนิคทินเลเยอร์โครมาโตกราฟี, หน้า 79-80. ใน บทคัดย่อการประชุมวิชาการแห่งชาติมหาวิทยาลัยเกษตรศาสตร์ วิทยาเขตกำแพงแสน ครั้งที่ 10. 6-7 ธันวาคม 2556. มหาวิทยาลัยเกษตรศาสตร์ วิทยาเขตกำแพงแสน, จ. นครปฐม. |
| มณี ตันติรุ่งกิจ, อรวรรณ ชวนตระกูล และ ภคพร สารทลาลัย. 2555. การศึกษาศักยภาพในการสร้างสารชีวภาพของยีสต์ทะเล, หน้า 1826-1836. ใน เรื่องเต็มการประชุมวิชาการแห่งชาติมหาวิทยาลัยเกษตรศาสตร์ วิทยาเขตกำแพงแสน ครั้งที่ 9. 6-7 ธันวาคม 2555. มหาวิทยาลัยเกษตรศาสตร์ วิทยาเขตกำแพงแสน, จ.นครปฐม. |
| มณี ตันติรุ่งกิจ, ชมนาถ เกิดคง, อรวรรณ ชวนตระกูล และ พัชราภรณ์ ภู่ไพบูลย์. 2551. ฤทธิ์ต้านจุลินทรีย์ของสารสกัดหยาบจากปาหมี. ใน นวัตกรรมงานวิจัยมหาวิทยาลัยเกษตรศาสตร์ ปี 2551. 30 เมษายน - 4 พฤษภาคม 2551. มหาวิทยาลัยเกษตรศาสตร์ บางเขน, กรุงเทพฯ. |
| มณี ตันติรุ่งกิจ, พัชราภรณ์ ภู่ไพบูลย์ และ อรวรรณ ชวนตระกูล. 2549. ฤทธิ์ต้านจุลินทรีย์ของสารสกัดหยาบจากเนระพูสีไทย. ใน บทคัดย่อการประชุมวิชาการวิทยาศาสตร์และเทคโนโลยีแห่งชาติ ครั้งที่ 32. 10-12ตุลาคม 2549. กรุงเทพฯ. |
| อภิตา บุญศิริ, จิตติมา จิรโพธิธรรม, ยุพิน อ่อนศิริ, มณี ตันติรุ่งกิจ, อรวรรณ ชวนตระกูล และ วิชัย สรพงษ์ไพศาล. 2558. การใช้โอโซนล้างกะเพราเพื่อรักษาคุณภาพและความปลอดภัยสำหรับผู้บริโภค. วารสารวิทยาศาสตร์เกษตร 46(3/1)(พิเศษ): 323-326. |
| อรวรรณ ชวนตระกูล, มณี ตันติรุ่งกิจ และ วุฒิชัย ทองดอนแอ. 2554. การคัดเลือกแบคทีเรียเพื่อใช้เป็นหัวเชื้อสำหรับทำปุ๋ยหมัก, หน้า1517 -1522. ใน การประชุมวิชาการระดับชาติมหาวิทยาลัยเกษตรศาสตร์ วิทยาเขตกำแพงแสน ครั้งที่ 8. 8-9 ธันวาคม 2554. มหาวิทยาลัยเกษตรศาสตร์ วิทยาเขตกำแพงแสน, จ.นครปฐม. |
| Kerdkhong C., M. Tantirungkij and O. Chountragoon. 2016. Diversity of yeasts isolated from fragrant flowers and their invertase activity, p. 131. In Abstracts of The 42nd Congress on Science and Technology of Thailand (STT 42). Nov. 30 - Dec. 2, 2016. Centara Grand, Central plaza Ladprao, Bangkok, Thailand. |
| Kerdkhong, C., O. Chountragoon and M. Tantirungkij. 2016. Diversity of yeasts associated with fragrant flowers, p. 255. In Abstract of The 14th International Congress on Yeasts (ICY2016). Sep. 11-15, 2016. Awaji Yumebutai International Conference Center, Awaji Island, Japan. |
| Tantirungkij, M., R. Nasanit and S. Limtong. 2015. Diversity of culture-independent endophytic yeasts from sugarcane leaves in Thailand, p. 86. In Abstract of ISSY32: International Specialized Symposium on Yeasts: Yeasts Biodiversity and Biotechnology in The Twenty-First Century. Sep. 13-17, 2015. Perugia, Italy. |
| Tantirungkij, M., O. Chountragoon and S. Limtong. 2009. Manipulation of Kluyveromyces marxianus for bioethanol production, p.70. In Abstracts of The 35th Congress on Science and Technology of Thailand (STT 35). Oct. 15-17, 2009. The Tide Resort (Bangsaen Beach), Chonburi, Thailand. |
| Tantirungkij, M., C. Kerdkhong, O. Chountragoon and S. Chaeychomsri. 2008. Molecular bacterial diversity in mangrove soil from KhoaLampi-Hat Tai Mueang National Park, Phangnga province. pp. 1-4. In Proceedings of The International Conference on Life Sciences 2008” Well Being for the Human Race” (BioAsia 2008, Thailand). Nov. 25-27, 2008. Bangkok, Thailand. |
| Tantirungkij, M., O. Chountragoon and P. Phupaibul. 2007. Antimicrobial activity of local medicinal plants: Tacca chantrieri & Linostoma pauciflorum, p. 140. In Abstract of The 6th Princess Chulabhorn International Science Congress; The interface of chemistry and biology in the “Omics” era: Environment & Health and Drug Discover. Nov. 25-29, 2007. Bangkok, Thailand. |
| Tantirungkij, M., O. Chountragoon and. S. Limtong. 2006. Molecular identification of yeast for alcoholic beverage fermentation by random amplified polymorphic DNA and microsattelite PCR-fingerprinting, p. 138. In Abstracts of The 18th Annual Meeting of the Thai Society for Biotechnology on Biotechnology: Benefits & Bioethics. Nov. 2-3, 2006. Bangkok, Thailand. |
บทความทางวิชาการ |
| มณี ตันติรุ่งกิจ. 2558. เรียนรู้เพื่อลดการปนเปื้อนของจุลินทรีย์ในผลิตภัณฑ์จากสมุนไพรไทย. วารสารเกษตรอภิรมย์ 2(7): 37-41. |
| มณี ตันติรุ่งกิจ. 2549. สมุนไพรไฮเทค: ทางเลือกใหม่ในการผลิตชีวเภสัชภัณฑ์. วารสารข่าวศูนย์ปฏิบัติการวิจัยและเรือนปลูกพืชทดลอง 20(2): 5-10. |
| สุรพันธ์ จิตวิริยนนท์, อุทัย คันโธ, สุกัญญา จัตตุพรพงษ์ และ มณี ตันติรุ่งกิจ. 2553. อิทธิพลของระดับอุณหภูมิในการอัดเม็ดอาหารสูตรมันสำปะหลังต่อปริมาณจุลินทรีย์ในระบบทางเดินอาหารสุกรระยะรุ่นและสมรรถภาพการผลิตของสุกรระยะรุ่น-ขุน. วารสารข่าวศูนย์ปฏิบัติการวิจัยและเรือนปลูกพืชทดลอง 24(1): 5-10. |
เอกสารประกอบการฝึกอบรม |
| ชมนาถ เกิดคง, ศิริพรรณ สุขขัง, สุลักษณ์ แจ่มจำรัส, ปิยะรัตน์ วิจักขณ์สังสิทธิ์, ภคพร สารทลาลัย, ศิริวรรณ ทิพรักษ์ และ ธนภัทร ปลื้มพวก. 2559. เจลแอลกอฮอล์สมุนไพรล้างมือ (Herbal Cleansing Gel), หน้า 7-16. ใน เอกสารประกอบการฝึกอบรมค่ายเยาวชนบริหารการเกษตร รุ่นที่ 10. 1 กันยายน 2559. ศูนย์ปฏิบัติการวิจัยและเรือนปลูกพืชทดลอง, ศูนย์วิจัยและบริการวิชาการ, คณะเกษตร กำแพงแสน, มหาวิทยาลัยเกษตรศาสตร์ วิทยาเขตกำแพงแสน, จ. นครปฐม. |
| มณี ตันติรุ่งกิจ. 2559. การควบคุมคุณภาพด้านจุลชีววิทยาของผลิตภัณฑ์จากสมุนไพร, หน้า 36-42. ใน เอกสารประกอบการฝึกอบรม “การถ่ายทอดเทคโนโลยีการผลิตและแปรรูปพืชเป็นผลิตภัณฑ์เพื่อสุขภาพ”. รุ่นที่ 1. 30 มิถุนายน – 1 กรกฎาคม 2559. วิทยาลัยชุมชนสมุทรสาคร อ. เมือง จ. สมุทรสาคร. และ รุ่นที่ 2. 7-8 กรกฎาคม 2559. วิทยาลัยชุมชนตราด อ. เมือง จ. ตราด. |
| มณี ตันติรุ่งกิจ, ชมนาถ เกิดคง และ อรวรรณ ชวนตระกูล. 2559. เจาะโลกจิ๋วผ่านเลนส์, หน้า 1-21. ใน เอกสารประกอบการฝึกอบรมโครงการค่ายวิทยาศาสตร์ โรงเรียนองค์การบริหารส่วนจังหวัดกระบี่. 27 มกราคม 2559. ศูนย์ปฏิบัติการวิจัยและเรือนปลูกพืชทดลอง, ศูนย์วิจัยและบริการวิชาการ, คณะเกษตร กำแพงแสน, มหาวิทยาลัยเกษตรศาสตร์ วิทยาเขตกำแพงแสน, จ. นครปฐม. |
| มณี ตันติรุ่งกิจ. 2558. การควบคุมคุณภาพด้านจุลชีววิทยาของผลิตภัณฑ์จากสมุนไพร, หน้า 74-82. ใน เอกสารประกอบการฝึกอบรม “การถ่ายทอดเทคโนโลยีการสกัดสารและแปรรูปเป็นผลิตภัณฑ์จากสมุนไพร”รุ่นที่ 1. 3-5 มิถุนายน 2558. และรุ่นที่ 2. 17-19 มิถุนายน 2558. ศูนย์ปฏิบัติการวิจัยและเรือนปลูกพืชทดลอง, ศูนย์วิจัยและบริการวิชาการ, คณะเกษตร กำแพงแสน, มหาวิทยาลัยเกษตรศาสตร์ วิทยาเขตกำแพงแสน, จ. นครปฐม. |
| มณี ตันติรุ่งกิจ. 2549. การควบคุมคุณภาพและการตรวจการปนเปื้อนของจุลินทรีย์ในสินค้าประเภทสมุนไพร, หน้า 44-61. ใน เอกสารประกอบการฝึกอบรม “การแปรรูปและการควบคุมคุณภาพผลิตภัณฑ์จากสมุนไพร”. 4-6, 18-20 และ 25-27 กรกฎาคม 2549. ศูนย์ปฏิบัติการวิจัยและเรือนปลูกพืชทดลอง, ศูนย์วิจัยและบริการวิชาการ, คณะเกษตร กำแพงแสน, มหาวิทยาลัยเกษตรศาสตร์ วิทยาเขตกำแพงแสน, จ. นครปฐม. |
| มณี ตันติรุ่งกิจ. 2549. การตรวจเอกลักษณ์พืชด้วยเทคนิคด้านอณูวิทยา, หน้า 62-67. ใน เอกสารประกอบการฝึกอบรม “การแปรรูปและการควบคุมคุณภาพผลิตภัณฑ์จากสมุนไพร”. 4-6, 18-20 และ 25-27 กรกฎาคม2549. ศูนย์ปฏิบัติการวิจัยและเรือนปลูกพืชทดลอง, ศูนย์วิจัยและบริการวิชาการ, คณะเกษตร กำแพงแสน, มหาวิทยาลัยเกษตรศาสตร์ วิทยาเขตกำแพงแสน, จ. นครปฐม. |
| อรวรรณ ชวนตระกูล. 2559. การทำไวน์สมุนไพร, หน้า 43-51. ใน เอกสารประกอบการฝึกอบรม “การถ่ายทอดเทคโนโลยีการผลิตและแปรรูปพืชเป็นผลิตภัณฑ์เพื่อสุขภาพ”. รุ่นที่ 1. 30 มิถุนายน – 1 กรกฎาคม 2559. วิทยาลัยชุมชนสมุทรสาคร อ. เมือง จ. สมุทรสาคร. และ รุ่นที่ 2. 7-8 กรกฎาคม 2559. วิทยาลัยชุมชนตราด อ. เมือง จ. ตราด. |
| อรวรรณ ชวนตระกูล. 2558. การทำไวน์สมุนไพร, หน้า 58-66. ใน เอกสารประกอบการฝึกอบรม “การถ่ายทอดเทคโนโลยีการสกัดสารและแปรรูปเป็นผลิตภัณฑ์จากสมุนไพร”. รุ่นที่ 1. 3-5 มิถุนายน 2558. และ รุ่นที่ 2. 17-19 มิถุนายน 2558. ศูนย์ปฏิบัติการวิจัยและเรือนปลูกพืชทดลอง, ศูนย์วิจัยและบริการวิชาการ, คณะเกษตร กำแพงแสน, มหาวิทยาลัยเกษตรศาสตร์ วิทยาเขตกำแพงแสน, จ. นครปฐม. |
| หน่วยจุลชีววิทยาประยุกต์. 2559. เอกสารประกอบการฝึกอบรมโครงการเสริมทักษะวิทยาศาสตร์ด้านจุลชีววิทยา. รุ่นที่ 5-8 (2556-2559). ศูนย์ปฏิบัติการวิจัยและเรือนปลูกพืชทดลอง ศูนย์วิจัยและบริการวิชาการ คณะเกษตร กำแพงแสน มหาวิทยาลัยเกษตรศาสตร์ วิทยาเขตกำแพงแสน จ. นครปฐม. |
| หน่วยจุลชีววิทยาประยุกต์. 2557. เอกสารประกอบการฝึกอบรมเชิงปฏิบัติการ เรื่อง การจัดจำแนกจุลินทรีย์ด้วยเทคนิคชีวโมเลกุล. รุ่นที่ 1. 20-22 สิงหาคม 2557. และ รุ่นที่ 2. 27-29 สิงหาคม 2557. ศูนย์ปฏิบัติการวิจัยและเรือนปลูกพืชทดลอง ศูนย์วิจัยและบริการวิชาการ คณะเกษตร กำแพงแสน มหาวิทยาลัยเกษตรศาสตร์ วิทยาเขตกำแพงแสน จ. นครปฐม. |
| หน่วยจุลชีววิทยาประยุกต์. 2555. เอกสารประกอบการฝึกอบรมโครงการเสริมทักษะวิทยาศาสตร์ด้านจุลชีววิทยา. รุ่นที่ 4. 22-23 มิถุนายน 2555. ศูนย์ปฏิบัติการวิจัยและเรือนปลูกพืชทดลอง ศูนย์วิจัยและบริการวิชาการ คณะเกษตร กำแพงแสน มหาวิทยาลัยเกษตรศาสตร์ วิทยาเขตกำแพงแสน จ. นครปฐม. |
| หน่วยจุลชีววิทยาประยุกต์. 2554. เอกสารประกอบการฝึกอบรมโครงการเสริมทักษะวิทยาศาสตร์ด้านจุลชีววิทยา. รุ่นที่ 3. 25-26 มิถุนายน 2554. ศูนย์ปฏิบัติการวิจัยและเรือนปลูกพืชทดลอง ศูนย์วิจัยและบริการวิชาการ คณะเกษตร กำแพงแสน มหาวิทยาลัยเกษตรศาสตร์ วิทยาเขตกำแพงแสน จ. นครปฐม. |
| หน่วยจุลชีววิทยาประยุกต์. 2553. เอกสารประกอบการฝึกอบรมโครงการเสริมทักษะวิทยาศาสตร์ด้านจุลชีววิทยา. รุ่นที่ 2. 19-20 มิถุนายน 2553. ศูนย์ปฏิบัติการวิจัยและเรือนปลูกพืชทดลอง ศูนย์วิจัยและบริการวิชาการ คณะเกษตร กำแพงแสน มหาวิทยาลัยเกษตรศาสตร์ วิทยาเขตกำแพงแสน จ. นครปฐม. |
| หน่วยจุลชีววิทยาประยุกต์. 2552. เอกสารประกอบการฝึกอบรมโครงการเสริมทักษะวิทยาศาสตร์ด้านจุลชีววิทยา. รุ่นที่ 1. 27-28 มิถุนายน 2552. ศูนย์ปฏิบัติการวิจัยและเรือนปลูกพืชทดลอง ศูนย์วิจัยและบริการวิชาการ คณะเกษตร กำแพงแสน มหาวิทยาลัยเกษตรศาสตร์ วิทยาเขตกำแพงแสน จ. นครปฐม. |
| หน่วยจุลชีววิทยาประยุกต์. 2550. เอกสารประกอบการฝึกอบรมเชิงปฏิบัติการ เรื่อง เทคนิคด้านชีวโมเลกุลเบื้องต้นเพื่อการศึกษาและวิจัยความหลากหลายของจุลินทรีย์. รุ่นที่ 1-6 (2548-2550). ศูนย์ปฏิบัติการวิจัยและเรือนปลูกพืชทดลอง ศูนย์วิจัยและบริการวิชาการ คณะเกษตร กำแพงแสน มหาวิทยาลัยเกษตรศาสตร์ วิทยาเขตกำแพงแสน จ. นครปฐม. |
ดาวน์โหลด
ภาพกิจกรรม
| ฝึกอบรม |
|
การจัดจำแนกจุลินทรีย์ด้วยเทคนิคชีวโมเลกุล รุ่นที่ 2 [27-29 สิงหาคม 2557] |
|
การจัดจำแนกจุลินทรีย์ด้วยเทคนิคชีวโมเลกุล รุ่นที่ 1 [20-22 สิงหาคม 2557] |
|
เทคนิคด้านชีวโมเลกุลเพื่อการศึกษาและวิจัยความหลากหลายของจุลินทรีย์ [21-23 พฤษภาคม 2550] |
|
เทคนิคด้านชีวโมเลกุลเพื่อการศึกษาและวิจัยความหลากหลายของจุลินทรีย์ [16-18 พฤษภาคม 2550] |
|
เทคนิคด้านชีวโมเลกุลเพื่อการศึกษาและวิจัยความหลากหลายของจุลินทรีย์ [18-20 พฤษภาคม 2549] |
|
เทคนิคด้านชีวโมเลกุลเพื่อการศึกษาและวิจัยความหลากหลายของจุลินทรีย์ [2-4 พฤษภาคม 2549] |
|
เทคนิคด้านชีวโมเลกุลเพื่อการศึกษาและวิจัยความหลากหลายของจุลินทรีย์ [22-24 พฤศจิกายน 2548] |
|
เทคนิคด้านชีวโมเลกุลเพื่อการศึกษาและวิจัยความหลากหลายของจุลินทรีย์ [15-27 พฤศจิกายน 2548] |
ศึกษาดูงาน |
|
คณะอาจารย์และนักศึกษา จาก Niigata University ประเทศญี่ปุ่น [7 มกราคม 2559] |
|
โรงเรียนมัธยมฐานบินกำแพงแสน ต.กระตีบ อ.กำแพงแสน จ.นครปฐม [23 กันยายน 2558] |
|
คณะอาจารย์และนิสิตระดับปริญญาตรี จาก Hokkaido University ประเทศญี่ปุ่น [4 กันยายน 2558] |
|
นักศึกษาสาขาวิชาชีววิทยา คณะวิทยาศาสตร์และเทคโนโลยี มหาวิทยาลัยราชภัฎหมู่บ้านจอมบึง จ. ราชบุรี [4 กันยายน 2558] |
|
นักศึกษาจากภาควิชา Agrotechnology คณะ Agrotechnology and Food Sciences, University Malaysia Terengganu ประเทศมาเลเซีย [26 มิถุนายน 2557] |
|
โรงเรียนจุฬาภรณ์ราชวิทยาลัย มุกดาหาร ต. บางทรายใหญ่ อ. เมืองมุกดาหาร จ. มุกดาหาร [30 สิงหาคม 2556] |
ค่ายวิทยาศาสตร์ |
|
โครงการค่ายวิทยาศาสตร์โรงเรียนองค์การบริหารส่วนจังหวัดกระบี่ [27-28 มกราคม 2559] |
|
ทักษะปฏิบัติการพื้นฐานจุลชีววิทยา รุ่นที่ 7 โรงเรียนเบญจมราชูทิศ ราชบุรี [27-28 มิถุนายน 2558] |
|
ทักษะปฏิบัติการพื้นฐานจุลชีววิทยา รุ่นที่ 6 โรงเรียนเบญจมราชูทิศ ราชบุรี [31 พฤษภาคม - 1 มิถุนายน 2557] |
|
ทักษะปฏิบัติการพื้นฐานจุลชีววิทยา รุ่นที่ 5 โรงเรียนเบญจมราชูทิศ ราชบุรี [22-23 มิถุนายน 2556] |
|
ทักษะปฏิบัติการพื้นฐานจุลชีววิทยา รุ่นที่ 4 โรงเรียนเบญจมราชูทิศ ราชบุรี [23-24 มิถุนายน 2555] |
|
ทักษะปฏิบัติการพื้นฐานจุลชีววิทยา รุ่นที่ 3 โรงเรียนเบญจมราชูทิศ ราชบุรี [25-26 มิถุนายน 2554] |
|
ทักษะปฏิบัติการพื้นฐานจุลชีววิทยา รุ่นที่ 2 โรงเรียนเบญจมราชูทิศ ราชบุรี [19-20 มิถุนายน 2553] |
|
ทักษะปฏิบัติการพื้นฐานจุลชีววิทยา รุ่นที่ 1 โรงเรียนเบญจมราชูทิศ ราชบุรี [27-28 มิถุนายน 2552] |
ฝึกงานนิสิต/นักศึกษา
 |
นักศึกษาชั้นปีที่ 3 สาขาวิชาย่อยเทคโนโลยีทางจุลินทรีย์ คณะวิทยาศาสตร์และเทคโนโลยีอุตสาหกรรม มหาวิทยาลัยสงขลานครินทร์ วิทยาเขตสุราษฎร์ธานี [25 พฤษภาคม-24 กรกฎาคม 2558] |
 |
นิสิตปริญญาตรีชั้นปีที่ 3 สาขาวิชาโรคพืช คณะเกษตร กำแพงแสน มหาวิทยาลัยเกษตรศาสตร์ วิทยาเขตกำแพงแสน [14 ตุลาคม 2556-31 ตุลาคม 2556] |
 |
นักศึกษาชั้นปีที่ 3 สาขาวิชาย่อยเทคโนโลยีการผลิตทางชีวภาพทั่วไป คณะวิทยาศาสตร์และเทคโนโลยีอุตสาหกรรม มหาวิทยาลัยสงขลานครินทร์ วิทยาเขตสุราษฎร์ธานี [25 มีนาคม-28 พฤษภาคม 2556] |
|